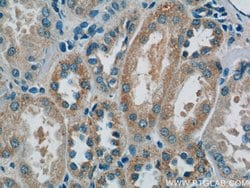
domain-I-of-FIZ-1 Rabbit anti-Human, Mouse, Rat, Polyclonal, Proteintech

missing translation for 'onlineSavingsMsg'
Learn More
Learn More
domain-I-of-FIZ-1 Rabbit anti-Human, Mouse, Rat, Polyclonal, Proteintech
Tienda Proteintech ProductosDescripción
FLJ14768 is homologous to mouse and bovine Fiz1 (flt-3 interacting zinc finger). It interacts with NRL (neural retina leucine zipper). Possible role for Fiz1 as a transcriptional repressor.
Especificaciones
Especificaciones
| Antígeno | domain-I-of-FIZ-1 |
| Aplicaciones | Immunofluorescence, Western Blot, Immunohistochemistry (Paraffin), Immunocytochemistry |
| Clasificación | Polyclonal |
| Concentración | 0.44 mg/mL |
| Conjugado | Unconjugated |
| Formulación | PBS with 50% glycerol and 0.02% sodium azide; pH 7.3 |
| génica | FIZ1 |
| N.º de referencia del gen | Q96SL8, Q9WTJ4 |
| Alias de gen | domain I of FIZ 1, domain II of FIZ1, FIZ1, FLT3 interacting zinc finger 1, Zinc finger protein 798, ZNF798 |
| Símbolos de los genes | FIZ1 |
| Mostrar más |
Título del producto
Indem Sie auf Absenden klicken, erklären Sie sich damit einverstanden, dass Fisher Scientific sich mit Ihnen in Verbindung setzen kann, um Ihr Feedback in diesem Formular zu bearbeiten. Wir werden Ihre Informationen nicht für andere Zwecke weitergeben. Alle bereitgestellten Kontaktinformationen werden in Übereinstimmung mit unserer Datenschutzrichtlinie aufbewahrt. Datenschutzrichtlinie.
Haben Sie Verbesserungsvorschläge?